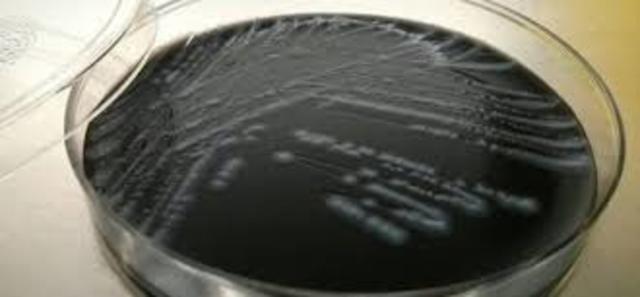
genoma de Legionella pneumophila,

-
1546: GirolamoFrascatoro estudia enfermedades contagiosas y propone una teoría sobre su origen.
-
1677-1684: Antón van Leeuwenhoek describe las primeras observaciones realizadas con microscopios caseros de los microorganismos (llamados entonces animáculos) presentes en agua de lluvia, fuentes, mar y nieve así como de muestras tomadas de materia interdenta
-
1789: Edward Jenner estudia la resistencia a la viruela que presentaban ciertos grupos de población y comienza el desarrollo de técnicas de vacunación.
-
1837: Lázaro Spallanzani comprobó que el tratamiento térmico repetido permitía evitar el crecimiento de microorganismos en infusiones. Supone un primer desarrollo de métodos de esterilización de líquidos
-
1837: Theodore Schwann realiza los primeros experimentos relacionados con la fermentación y la putrefacción originados por microorganismos
-
Ø 1838: Charles Cagniard-Latour, memoria sobre la fermentación alcohólica.
-
1857-1861: Louis Pasteur realiza una serie de experimentos que demuestran el origen microbio de procesos de fermentación láctica, alcohólica, existencia de microorganismos anaerobios y demuestra que sólo puede producirse crecimiento microbio a partir de microorganismos preexistentes.
-
Joseph Lister desarrolla el principio de la asepsia en la práctica quirúrgica.
-
Robert Koch realiza varios estudios sobre los agentes causantes de diversas enfermedades infecciosas
-
Desarrolla un método que permite la esterilización de líquidos que contienen esporas de bacilos.
-
desarrolla vacunas frente a varias enfermedades víricas.
-
Robert Koch realiza varios estudios sobre los agentes causantes de diversas enfermedades infecciosas.
-
desarrolla su método de tinción de bacterias.
-
descubre las bacterias que nodulan las leguminosas
-
realiza los primeros estudios sobre los efectos geoquímicos producidos por bacterias.
-
M.V.Beijerinck aisló el primer virus vegetal (Mosaico del tabaco).
-
desarrolla los primeros métodos quimioterápicos
-
descubre el primer virus bacteriano (bacteriófago).
-
Alexander Fleming descubre la penicilina
-
describen el agente causante de la glosopeda (fiebre aftosa): aislamiento de virus animales
-
Clements y Bullivant descubren Epulopiscium fishelsoni, la mayor célula procariota
-
descubren que Vibrio cholerae tiene dos cromosomas circulares
-
Hopwood y col. realizaron la secuenciación del genoma de Streptomyces coelicolor.
-
aparece en Asia la gripe aviar, producida por el subtipo H5N1 del virus Influenza A que puede transmitirse al hombre.
-
Secuenciación del genoma de Legionella pneumophila, el microorganismo productor de la enfermedad de los legionarios.
-
se secuencia el genoma del Saccharopolyspora erythraea, el microorganismo productor del antibiótico eritromicina.
-
en México aparece un brote de gripe porcina, posteriormente llamada gripe A H1N1.
-
se descubre el proceso de esporulación en Mycobacterium
-
Bacillus subtilis puede producir dos esporas en la misma célula madre
-
caracterización "in vivo" e "in vitro" del virus H1N1.
Plan projects on a visual timeline
Map milestones, phases, deadlines, and key events in one place so the sequence is easier to see and share. Timetoast is a timeline maker for work, school, research, and stories.